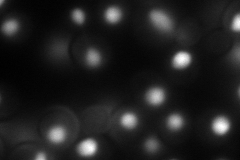
YOL123W
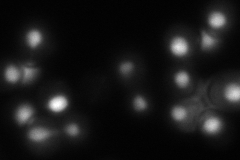
YOL123W
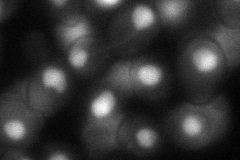
YOL123W

View description
Subunit of cleavage factor I, a five-subunit complex required for the cleavage and polyadenylation of pre-mRNA 3' ends; RRM-containing heteronuclear RNA binding protein and hnRNPA/B family member that binds to poly (A) signal sequences
Localization:
Intensity:
Fold change:
Significance:
-
C’ GFP library in SD

nucleus244.39 -
N' NOP1pr-GFP in SD
nucleus138.278 -
N' TEF2pr-mCherry in SD

missing0 -
N' NATIVEpr-GFP in SD
nucleus145.183 -
N' TEF2pr-VC and Cyto-VN in SD
nucleus73.5314 -
C’ GFP library in SD+DTT

nucleus266.71.09No -
C’ GFP library in SD+H2O2

nucleus275.251.12No -
C’ GFP library in Starvation Media

nucleus217.80.89No -
C’ GFP library on the background of Pup2-DaMP

nucleus -
C’ GFP library on the background of CCT mutant

nucleus262.2381.07299No
